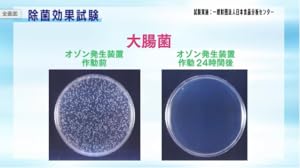
Amazon | Airness (エアネス) 低濃度オゾン発生装置 ANS-1601 | Maxell

Airnessオゾン発生器 ANS1601 エアネス(Airness/ANS-1601) | オゾンプラス
(3911件)
Pontaパス特典
サンキュー配送
6960円(税込)
70ポイント(1%)
Pontaパス会員ならさらに+1%ポイント還元!
送料
(
)
3904
配送情報
お届け予定日:2026.05.31 10:46までにお届け
※一部地域・離島につきましては、表示のお届け予定日期間内にお届けできない場合があります。
ロットナンバー
701518856
お買い物の前にチェック!

Pontaパス会員なら
ポイント+1%
ポイント+1%
商品説明



新品未開封品空気を綺麗にするとともに、臭いを取ることができますオゾン脱臭、空気清浄機能これからの季節の感染症対策に是非。
| カテゴリー: | 生活家電・空調>>>空気清浄機・イオン発生器>>>オゾン発生器 |
|---|---|
| 商品の状態: | 新品、未使用","新品で購入し、一度も使用していない |
| 配送料の負担: | 送料込み(出品者負担) |
| 配送の方法: | 郵便(定型、定形外、書留など) |
| 発送元の地域: | 宮城県 |
| 発送までの日数: | 2~3日で発送 |
レビュー
商品の評価:




 4.5点(3911件)
4.5点(3911件)
- 結芽tan
- 以前は、3種類の液体を使っていましたが、これ1本ですむので、とても気に入ってます。
- パクチー娘
- 迅速でご丁寧な対応に満足しています。 またリピートすると思います。
- にこにこ ワクワク
- コンタクトレンズのケースがおまけについてます。あまり買い換えるものではないので意外と嬉しいです。ウチはカミさんもコンタクトなので、まとめ買いしています。
- もるもるじょん
- モノケアをいつも使っているので安心です。240mLでサイズが多きのがいいです。
- おぞみか
- 同商品を近所のドラッグストアなどで購入すると1つ900円ほどします。 レビューを書いて15個で4800円なので1つ320円と大満足です。
- Lee8906
- いつも近所の薬局等で購入している商品と同じなので問題なしです。
すべて見る
お店の情報
7,367
連絡・応対
4.3
配送スピード
4.3
梱包
4.3